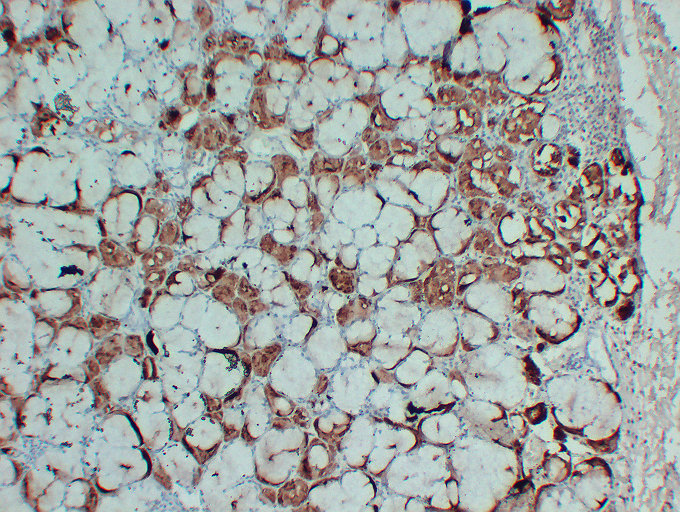

GCDFP 15 Mouse mAb(IHC专用)
产品介绍
Belongs to the PIP family.
产品性质
产品特色
推荐稀释比 IHC:1/100-1/500
应用案例
Immunohistochemistry analysis of paraffin-embedded Human Salivary glands using GCDFP 15 antibody.High-pressure and temperature Sodium Citrate pH 6.0 was used for antigen retrieval.

Immunohistochemistry analysis of paraffin-embedded Human Skin using GCDFP 15 antibody.High-pressure and temperature Sodium Citrate pH 6.0 was used for antigen retrieval.
存储条件
-25 ~ -15℃保存,收到货之后有效期1年,避免反复冻融。
COA
已发表文献
相关产品
联系我们





